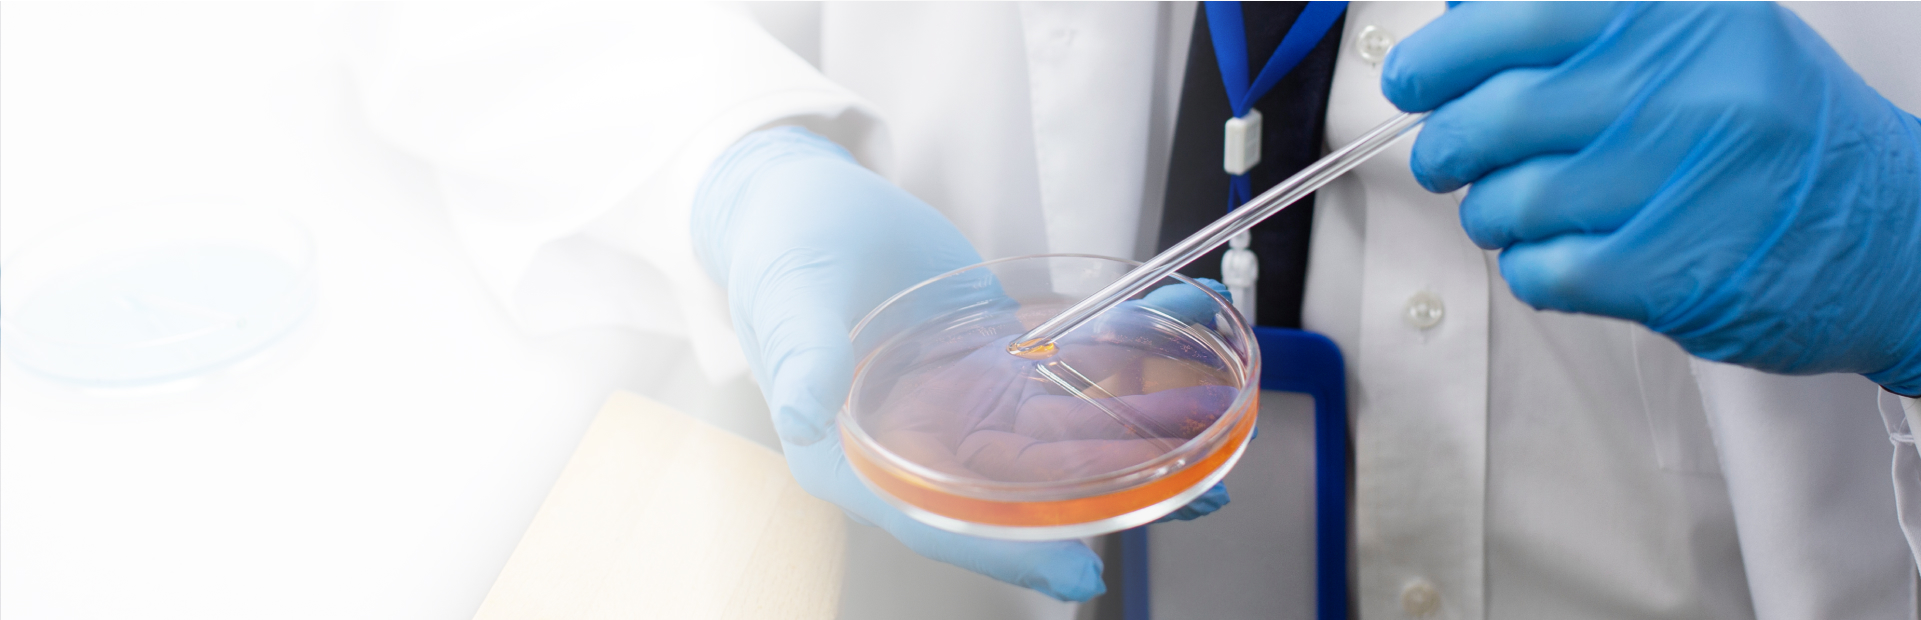
banner

Inventing and
Innovating
Tomorrows Technolgy
- Engage with IIT H

Inventing and
Innovating
Tomorrows Technolgy
- Engage with IIT H
Inventing and
Innovating
Tomorrows Technolgy
- Engage with IIT H










